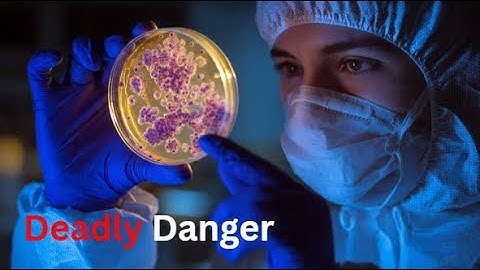

⬇ DOWNLOAD NOW
Kalau muncul iklan pop-up, tutup lalu klik tombol kembali
Download lagu Invasive fungal infections - The new threat | DW Documentary secara gratis hanya untuk keperluan promosi. Dukung artis favorit kamu dengan membeli musik original di iTunes atau platform resmi lainnya.
Invasive fungal infections - The new threat Documentary
Invasive fungal infections - The new threat Documentary
 This Fungus Is Spreading Rapidly in Hospitals
This Fungus Is Spreading Rapidly in Hospitals
 Fungal Invaders: Why Deadly Fungi Are the Next Global Health Threat
Fungal Invaders: Why Deadly Fungi Are the Next Global Health Threat
 "Hidden Dangers of Fungal Infections You Shouldn’t Ignore"
"Hidden Dangers of Fungal Infections You Shouldn’t Ignore"
 CDC: Drug-resistant yeast in New York is "global emerging threat"
CDC: Drug-resistant yeast in New York is "global emerging threat"
 Hidden Virus Boosts Deadly Fungal Infections: New Discovery Explained
Hidden Virus Boosts Deadly Fungal Infections: New Discovery Explained
 Tackling the global threat of invasive fungal pathogens
Tackling the global threat of invasive fungal pathogens
 AMR Exchange: Antifungal Resistance: Understanding this Growing Global Threat
AMR Exchange: Antifungal Resistance: Understanding this Growing Global Threat